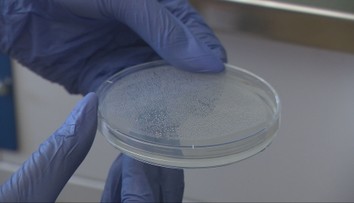
Hygienici stále testujú vzorky z kúpaliska v Štúrove. Boli sme sa pozrieť, ako skúmajú améby priamo v laboratóriách

Testovať sa bude po novom, zapoja sa aj súkromné laboratóriá. Tu sú pravidlá

Premiér Matovič uviedol, že odberné miesto bude pred každou nemocnicou.
Okrem zástupcov laboratórií boli na tlačovom brífingu prítomní aj minister zdravotníctva Marek Krajčí, hlavný hygienik Ján Mikas a členovia permanentného krízového štábu.
Igor Matovič na brífingu zopakoval, že mimoriadne dôležité je ľudí masívne testovať na nový koronavírus. Nie však rýchlotestami, ale genetickým testovaním výtermi z nosa a úst.
S Asociáciou súkromných laboratórií sa podľa slov Matoviča štát dohodol, že zapoja všetky kapacity, ktoré môžu poskytnúť.
Peter Lednický z asociácie poznamenal, že denne súkromné laboratóriá môžu urobiť zhruba 1200 testov, pričom každý deň sa môže tento počet zvyšovať. Od budúceho týždňa by to mohlo byť už 2000.
Hlavný hygienik Ján Mikas poznamenal, že vďaka zapojeniu sa štátnych laboratórií sa skráti doba čakania na výsledok a zvýši sa aj kapacita vyšetrených vzoriek denne.
Premiér doplnil, že doteraz išli na testy len ľudia, ktorí prešli kritériami a aj vtedy čakali na testy niekoľko dní. Dôvodom podľa Matoviča bolo i to, že záchranári nemali ochranné pomôcky. Minister Krajčí tvrdí, že týmto krokom sa zabezpečí "dostať epidémiu čo najdlhšie pod kontrolu".
Okrem toho má podľa Matoviča pribudnúť pred každou nemocnicou vonkajšie odberné miesto, vďaka ktorému budú chránení pacienti, ktorí nemajú podozrenie na tento druh ochorenia.
Ako potvrdil, súkromné laboratóriá zabezpečia zvoz odobratých vzoriek do všetkých laboratórií bez ohľadu na to, či je štátne alebo súkromné.
Výsledok z testovania na nový koronavírus po novom podľa premiéra dostanú aj ľudia, ktorí budú mať negatívny výsledok, nielen tí, čo ho majú pozitívny.
"Chceme, aby pozitívny výsledok oznamovali ľudia, ktorí sú na to vyškolení," povedal premiér. Krajčí dodal, že informáciu o tom, že je pacient pozitívny na nový koronavírus, dostane aj jeho všeobecný lekár. "Jeho úlohou bude pozitívne testovaného pacienta v rizikovej skupine 65 plus každý deň kontaktovať," uzavrel minister.
Vzorky budú následne pracovníci rozvážať do najbližšieho laboratória. Asociácia súkromných laboratórií sa s vládou dohodla, že rozvoz budú robiť bez honoráru.
Testovať nebudú kohokoľvek, kto má záujem
K diskusii sa pridali aj zdravotné poisťovne. Generálna riaditeľka VŠZP Ľubica Hlinková uviedla, že poisťovne budú hradiť testovanie aj súkromnými laboratóriami.
Matovič spresnil, že testovať sa nebude môcť nechať ktokoľvek, kto má záujem. Pacienta musí doporučiť jeho lekár. Nevylúčil, že časom bude možné testovať aj širokú verejnosť.
Podľa premiéra by bolo vhodné, aby sa testovali aj ľudia z kritickej infraštruktúry, ktorí pracujú v sektoroch kľúčových pri fungovaní štátu. Matovič tvrdí, že súkromné laborátoriá by mohli testovať aj fabriky s väčším počtom zamestnancov, ak o to budú mať firmy záujem.
Ďalšie kroky predstavil aj vedec Robert Mistrík. Podľa neho sa pripravuje aj mobilná aplikácia, prostredníctvom ktorej používatelia dostanú vlastný kód a s tým môžu ísť na odberné miesto.
Práve sa číta
Sledujte Televízne noviny vo full HD a bez reklám na Voyo